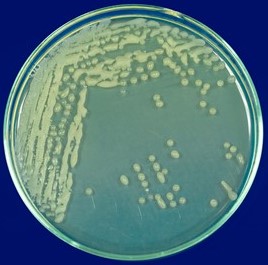

Bacillaceae
Esta familia pertenece al orden Bacillales. Cuenta con 78 géneros descritos (Taxonomy Browser- NCBI). Los miembros de esta familia son aerobios o anaerobios facultativos quimio organótrofos. La mayoría de estas bacterias incluyen bacilos Gram positivos formadores de endosporas. Sin embargo, existen excepciones a estas características, pues la familia cuenta con anaerobios estrictos, autótrofos, cocos y organismos que no forman endosporas. Algunas bacterias pueden ser Gram variables (Logan and Vos, 2015). Dentro de esta familia se encuentra el génereo Bacillus, en diferentes ambientes (suelo, mar, agua, alimentos, plantas). Las bacterias de este género que se utilizan en agricultura han sido ampliamente conocidas por su capacidad biocontroladora de enfermedades importantes a nivel agronómico (Niu et al., 2011; Senthilkumar et al., 2008), y también se ha demostrado que tienen la capacidad de promover el crecimiento de su huésped mediante actividades de solubilización de fosfatos, producción de sideróforos y reguladores de crecimiento vegetal (Chang et al., 2007; Idriss et al., 2002; Wahyudi et al., 2011). Estudios de interacción de estas bacterias con las plantas han permitido observar capacidades interesantes, como la promoción de crecimiento sin contacto con su huésped mediante producción de compuestos orgánicos volátiles (Kumar et al., 2012).